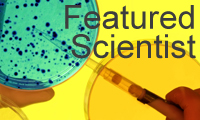

Contact Us
David Katz
PROGRAM DIRECTOR
Address:
Whitehead Biomedical Research Building
Room 443
Room 443
Phone:
Email:
Jie Jiang
DIRECTOR OF GRADUATE STUDIES (First-Year to Candidacy)
Address:
Whitehead Biomedical Research Building
Room 405D
Room 405D
Phone:
Email:
Ken Moberg
DIRECTOR OF GRADUATE STUDIES (Candidacy to Graduation)
Address:
Whitehead Biomedical Research Building
Room 442
Room 442
Phone:
Email:
Jennifer Spangle
ADMISSIONS DIRECTOR
Address:
Winship Cancer Institute
Room 3002
Room 3002
Email:
Email:
Roger Deal
ADMISSIONS CO-DIRECTOR
Address:
O. Wayne Rollins Research Center
Room 2017
Room 2017
Email:
Email:
Holley Butkovich
PROGRAM ADMINISTRATOR
Address:
1462 Clifton Road Building
Suite 300A
Suite 300A
Phone:
Email: